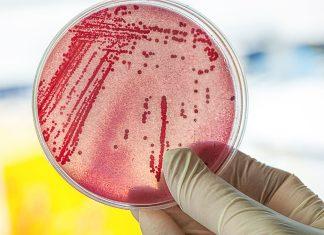
Aumentan casos tras brote de E.Coli en guarderías

El Carnaval del Caribe de Toronto se hizo sentir en la ciudad
El verano es tiempo para disfrutar de las actividades al aire libre que abundan en la ciudad más multicultural de Canadá. Una de las de mayor alcance se realizó el sábado pasado,...
Nos perdimos y olvidamos el significado de la solidaridad
¿Qué es lo que nos pasa como humanidad? ¿Acaso perdimos la razón?
Vivimos en un mundo crecientemente confuso, en el que pesan más los sentimientos y creencias personales que...
Aumentan casos tras brote de E.Coli en guarderías
Los Servicios de Salud de la provincia canadiense de Alberta informaron que los casos de niños contagiados con la bacteria Escherichia coli (E. coli) aumentaron a 190 tras el brote desatado en...
OPS llama a cambiar la narrativa estigmatizante sobre el suicidio
Al celebrarse el 10 de septiembre el Día Mundial para la Prevención del Suicidio, la Organización Panamericana de la Salud (OPS) llamó a reemplazar la narrativa estigmatizante sobre este actuar y fomentar...
Estragos de incendios forestales en Canadá tienen en 2023 su peor año
Canadá superó el récord de área quemada por incendios forestales en un solo año, mientras cientos de fuegos aún arden en casi todas las provincias y territorios, según una información de una...
Fuertes nevadas y bajas temperaturas en las primeras semanas de 2022
Ontario, British Columbia, Quebec y otras regiones de Canadá viven las primeras semanas de 2022 con bajas temperaturas y fuertes nevadas. Environment Canada aconsejó previamente a los residentes de estas regiones prepararse...
El Verdadero Valor de la Educación
Desde que era niña, las palabras de mi mamá quedaron arraigadas en mi memoria: “La educación puede transformar tu vida.”
Mi mamá, como muchas otras personas, no tuvo acceso...
Hacia la “nueva normalidad”: desde la sed de besos hasta el “síndrome de la...
En ediciones anteriores hemos repasado algunos de los riesgos que suponen, para la salud mental, el confinamiento y las medidas de alejamiento físico que se han debido implementar en la casi totalidad...
Canadá defiende soberanía de Groenlandia
Ante las amenazas reiteradas del presidente de Estados Unidos, Donald Trump, de anexar Groenlandia, Canadá adoptó una postura oficial de apoyo a la soberanía danesa, mientras que expertos y analistas advierten sobre...
El oscurantismo del siglo XXI
Hace algunas semanas, escuchando noticias en la CBC, me encontré con una investigación de The Fifth Estate que me sorprendió y me dejó muy preocupada. Recomiendo leerla y escuchar el video que...